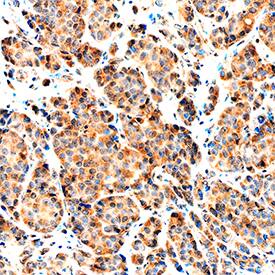
NRG1-beta 1/HRG1-beta 1 antibody in Human Breast by Immunohistochemistry (IHC-P).

Human NRG1-beta 1/HRG1-beta 1 EGF Domain Antibody
R&D Systems, part of Bio-Techne | Catalog # AF-396-NA


Key Product Details
Species Reactivity
Validated:
Cited:
Applications
Validated:
Cited:
Label
Antibody Source
Product Specifications
Immunogen
Thr176-Lys246
Accession # NP_039250
Specificity
Clonality
Host
Isotype
Endotoxin Level
Scientific Data Images for Human NRG1-beta 1/HRG1-beta 1 EGF Domain Antibody
Cell Proliferation Induced by NRG1‑ beta1/HRG1‑ beta1 and Neutralization by Human NRG1‑ beta1/HRG1‑ beta1 Antibody.
Recombinant Human NRG1-beta 1/ HRG1-beta 1 EGF Domain (Catalog # 396-HB) stimulates proliferation in the MCF-7 human breast cancer cell line in a dose-dependent manner (orange line). Proliferation elicited by Recombinant Human NRG1-beta 1/ HRG1-beta 1 EGF Domain (0.75 ng/mL) is neutralized (green line) by increasing concentrations of Goat Anti-Human NRG1-beta 1/HRG1-beta 1 EGF Domain Antigen Affinity-purified Polyclonal Antibody (Catalog # AF-396-NA). The ND50 is typically 0.5-2.0 µg/mL.NRG1‑ beta1/HRG1‑ beta1 in Human Breast .
NRG1-beta 1/HRG1-beta 1 was detected in immersion fixed paraffin-embedded sections of human breast using Goat Anti-Human NRG1-beta 1/HRG1-beta 1 EGF Domain Antigen Affinity-purified Polyclonal Antibody (Catalog # AF-396-NA) at 1 µg/mL overnight at 4 °C. Tissue was stained using the Anti-Goat HRP-DAB Cell & Tissue Staining Kit (brown; Catalog # CTS008) and counterstained with hematoxylin (blue). Specific staining was localized to cytoplasm. View our protocol for Chromogenic IHC Staining of Paraffin-embedded Tissue Sections.Applications for Human NRG1-beta 1/HRG1-beta 1 EGF Domain Antibody
Immunohistochemistry
Sample: Immersion fixed paraffin-embedded sections of human breast
Western Blot
Sample: Recombinant Human NRG1-beta 1/HRG1-beta 1 EGF Domain (Catalog # 396-HB)
Neutralization
Formulation, Preparation, and Storage
Purification
Reconstitution
Formulation
Shipping
Stability & Storage
- 12 months from date of receipt, -20 to -70 °C as supplied.
- 1 month, 2 to 8 °C under sterile conditions after reconstitution.
- 6 months, -20 to -70 °C under sterile conditions after reconstitution.
Background: Neuregulin-1 beta 1/NRG1 beta 1
The neuregulin family of structurally related glycoproteins comprises products from four distinct but related genes, Nrg-1, Nrg-2, Nrg-3, and Nrg-4. Through alternative splicing or the use of alternative promoters, Nrg-1 has been shown to encode more than 14 soluble or transmembrane proteins. The extracellular domain of the transmembrane NRG1 isoforms can be proteolytically cleaved to release soluble growth factors. All NRG1 isoforms contain an EGF‑like domain ( alpha- or beta-splice variant that differ in their C-terminal region) that is required for their direct binding to the ErbB3 or ErbB4 receptor tyrosine kinases. The ErbB3 or ErbB4 subsequently recruits and heterodimerizes with ErbB2, resulting in tyrosine phosphorylation and NRG1 signaling. NRG1 isoforms can be classified into three major subtypes. Type I (Neu Differentiation Factor, NDF; Heregulin, HRG; Acetylcholine Receptor Inducing Activity, ARIA) and type II (Glial Growth Factor, GGF) NRG1s have an immunoglobulin (Ig)-like domain N-terminal to the EGF‑like domain. Type I NRG1s differ from type II NRG1s by having a glycosylation-rich domain between the Ig‑like and the EGF‑like domains. Type III NRG1s (Sensory and Motor neuron-Derived Factor) lacks the Ig‑like domain but has a cysteine rich domain (CRD) instead. NRG1 isoforms show distinct spatial and temporal expression patterns. These proteins play important roles during development of both the nervous system and the heart. They have been shown to regulate the selective expression of neurotransmitter receptors in neurons and at the neuromuscular junction, and promote the differentiation and development of Schwann cells from neural crest stem cells. NRG1s have also been shown to be involved in the establishment of the oligodendroglial lineage.
References
- Buonanno, A., and Fischbach, G.D. (2001) Curr. Opin. Neurobiol. 11:287.
- Adlkofer, K. and Lai, C. (2000) Glia 29:104.
- Garratt, A.N. et al. (2000) BioEssays 22:987.
Alternate Names
Gene Symbol
UniProt
Additional Neuregulin-1 beta 1/NRG1 beta 1 Products
Product Documents for Human NRG1-beta 1/HRG1-beta 1 EGF Domain Antibody
Product Specific Notices for Human NRG1-beta 1/HRG1-beta 1 EGF Domain Antibody
For research use only